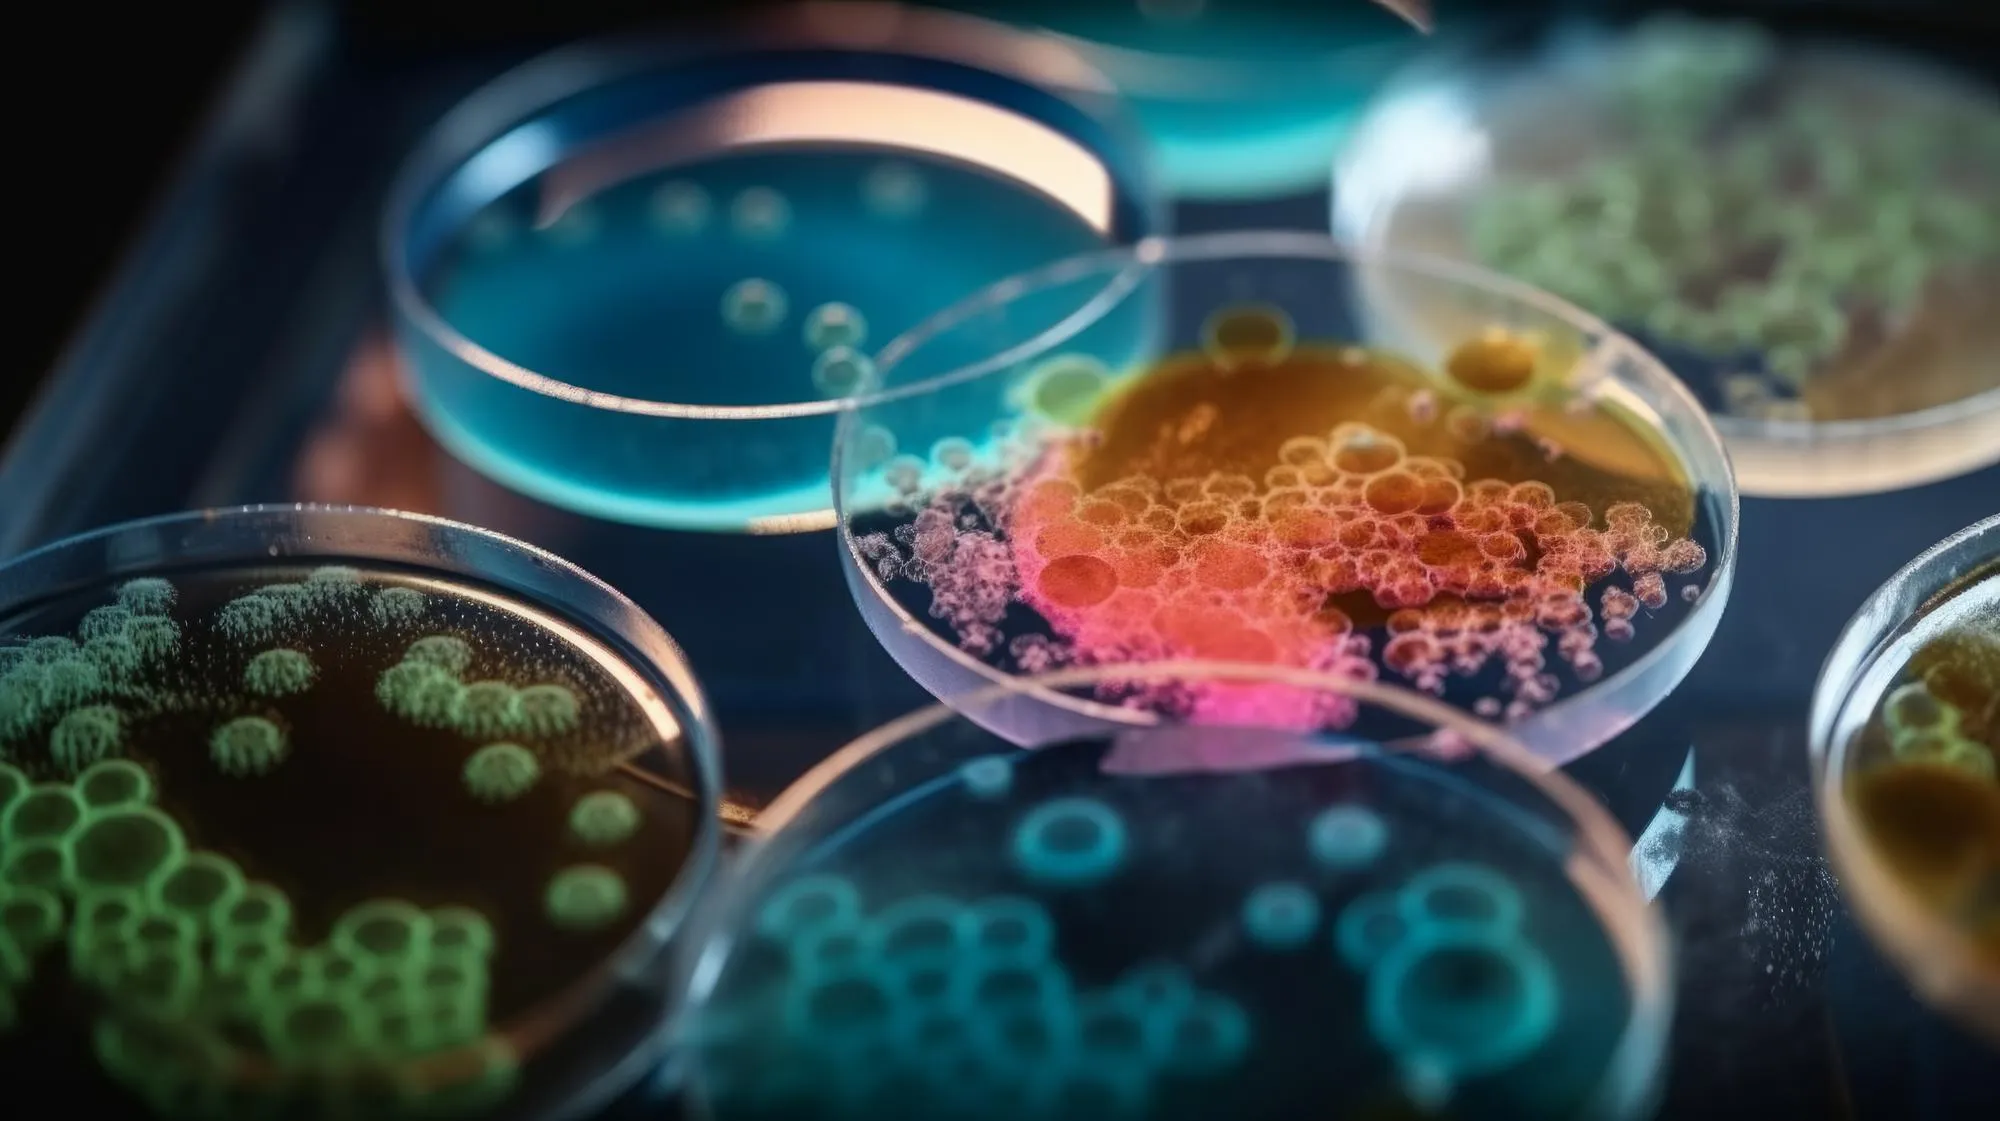
E.Coli Tolerance

In a groundbreaking study published in the Journal of Bacteriology, an international consortium of scientists has unearthed pivotal insights into the antibiotic resistance mechanisms employed by Escherichia coli cells during the formative stages of biofilm development. Contrary to the widely held notion that biofilm-associated cells exhibit universal tolerance to antibiotics, this study sheds light on a phase wherein E. coli cells show a comparable susceptibility to antibiotics as their free-floating, or planktonic, counterparts.
Investigating Early Biofilm Resistance Patterns
The collaborative effort led by Huan Gu, Sang Won Lee, Joseph Carnicelli, Zhaowei Jiang, and Dacheng Ren from Syracuse University delves beyond the surface of biofilm formation, exploring the transient antibiotic susceptibilities that may hold the key to developing more effective treatments against biofilm-related infections. DOI: 10.1128/JB.00034-19 details the complete findings of the study, which is supported by the National Institutes of Health (NIH) under grant numbers R21 AI142424 and S10 OD023617.
The Persisting Problem of Biofilms
Biofilms represent a formidable challenge in clinical settings, as they are implicated in over 80% of microbial infections in the human body, according to the National Institutes of Health. These complex assemblies of bacteria can adhere to a multitude of surfaces, from medical devices to human tissue, and are characterized by their high-level tolerance to antimicrobial agents—up to 1,000 times that of planktonic cells (Flemming et al., 2016; Hall & Mah, 2017).
Groundbreaking Experimental Design and Results
In a meticulously designed research paradigm, the Syracuse University team employed innovative techniques to cultivate patterned biofilms and subsequently examine the antibiotic tolerance of E. coli cells at various stages of biofilm maturation. The researchers discovered that during early biofilm formation, E. coli cells are as vulnerable to antibiotics as planktonic cells—a striking divergence from later stages where biofilm-embedded bacteria exhibit heightened resistance.
Implications for Treatment Strategies
This revelation potentially transforms our approach to tackling biofilm-associated infections. Understanding the window of opportunity during which biofilm cells remain susceptible to antibiotics can lead to the development of new therapeutic strategies, including the timely administration of antimicrobials to prevent mature biofilm formation (Ren et al., 2018).
References
1. Flemming, H. C., Wingender, J., Szewzyk, U., Steinberg, P., Rice, S. A., & Kjelleberg, S. (2016). Biofilms: an emergent form of bacterial life. Nature Reviews Microbiology, 14(9), 563–575. doi:10.1038/nrmicro.2016.94
2. Hall, C. W., & Mah, T. F. (2017). Molecular mechanisms of biofilm-based antibiotic resistance and tolerance in pathogenic bacteria. FEMS Microbiology Reviews, 41(3), 276–301. doi:10.1093/femsre/fux010
3. Ren, D., Madsen, J. S., Sørensen, S. J., & Burmølle, M. (2018). High prevalence of biofilm synergy among bacterial soil isolates in cocultures indicates bacterial interspecific cooperation. The ISME Journal, 12(1), 81–89. doi:10.1038/ismej.2017.135
4. Gu, H., Hou, S., Yongyat, C., De Tore, S., & Ren, D. (2013). Patterned biofilm formation reveals a mechanism for structural heterogeneity in bacterial biofilms. Langmuir, 29(36), 11145–11153. doi:10.1021/la402608z
5. Gu, H., Lee, S. W., Carnicelli, J., Jiang, Z., & Ren, D. (2019). Antibiotic susceptibility of Escherichia coli cells during early-stage biofilm formation. Journal of Bacteriology, 201(18), e00034-19. doi:10.1128/JB.00034-19
Keywords
1. Early-stage biofilm antibiotic susceptibility
2. Escherichia coli biofilm formation
3. Antibiotic resistance in biofilms
4. Biofilm treatment strategies
5. E. coli antibiotic tolerance
Conclusion
The study conducted by Gu et al. (2019) stands as a testament to the evolution in our comprehension of biofilm biology and antibiotic resistance. It underscores the importance of early intervention in the prevention of biofilm consolidation and paves the way for individualized, phase-dependent therapeutic regimens that could prove pivotal in the ongoing battle against bacterial infections and antibiotic tolerance. Moving forward, the medical community awaits with anticipation as developments stemming from these findings could revolutionize the treatment of biofilm-associated diseases.